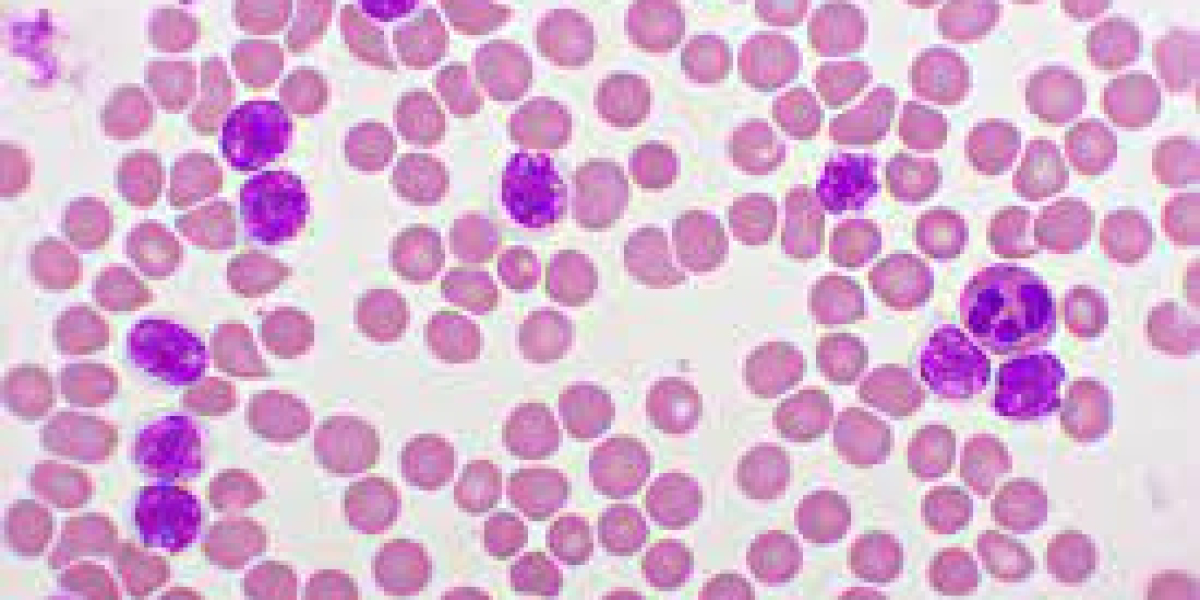
Chronic Lymphocytic Leukemia Market Size, Growth, Analysis & Industry Trends 2023-2033

Gentle Groove CBD Gummies Reviews and Buy
ORDER NOW : http://healthyifyshop.com/OrderGentleGrooveCBDGummies
Gentle Groove CBD Gummies, Users have reported relief from various ailments, with many citing improved sleep, reduced anxiety, and an overall sense of well-being. A convenient way to incorporate CBD into their daily routine, making it easier to manage their health and well-being.
Facebook Pages:
https://www.facebook.com/GentleGrooveCBDGummiesPage/
https://www.facebook.com/GentleGrooveCBDGummiesView/
For More Information :
https://sites.google.com/view/gentle-groove-cbd-scam/home
https://sites.google.com/view/gentle-groove-cbd-side-effects/home
https://gentle-groove-cbd-gummies-review.blogspot.com/2023/12/gentle-groove-cbd-gummies-reviews-hoax.html
https://www.linkedin.com/events/gentlegroovecbdgummiesreviews207140245671541903360/comments/
https://gentle-groove-cbd-gummies-review.hashnode.dev/gentle-groove-cbd-gummies-300mg-reviews-relieves-stress-pain-discomfort-easily-price
https://soundcloud.com/gentle-groom-cbd-gummies-buy/gentle-groove-cbd-gummies-price
https://medium.com/@gentlegroomcbdgummies/gentle-groove-cbd-gummies-reviews-scam-or-legit-dont-buy-till-you-read-e61860208054
https://in.pinterest.com/jha18071/gentle-groove-cbd-gummies-sale/
https://www.facebook.com/SupermaxMaleEnhancement/
https://sites.google.com/view/supermax-male-review/home
https://supermax-male-enhancement-review.blogspot.com/2023/12/supermax-male-enhancement-review-boost.html
https://www.linkedin.com/events/supermaxmaleenhancement-improve7138809500244795392/
https://supermax-male-enhancement.hashnode.dev/supermax-male-enhancement-review-sexual-nutrients-to-boost-testosterone
Gentle Groove CBD Gummies, Users have reported relief from various ailments, with many citing improved sleep, reduced anxiety, and an overall sense of well-being. A convenient way to incorporate CBD into their daily routine, making it easier to manage their health and well-being.
Facebook Pages:
https://www.facebook.com/GentleGrooveCBDGummiesPage/
https://www.facebook.com/GentleGrooveCBDGummiesView/
For More Information :
https://sites.google.com/view/gentle-groove-cbd-scam/home
https://sites.google.com/view/gentle-groove-cbd-side-effects/home
https://gentle-groove-cbd-gummies-review.blogspot.com/2023/12/gentle-groove-cbd-gummies-reviews-hoax.html
https://www.linkedin.com/events/gentlegroovecbdgummiesreviews207140245671541903360/comments/
https://gentle-groove-cbd-gummies-review.hashnode.dev/gentle-groove-cbd-gummies-300mg-reviews-relieves-stress-pain-discomfort-easily-price
https://soundcloud.com/gentle-groom-cbd-gummies-buy/gentle-groove-cbd-gummies-price
https://medium.com/@gentlegroomcbdgummies/gentle-groove-cbd-gummies-reviews-scam-or-legit-dont-buy-till-you-read-e61860208054
https://in.pinterest.com/jha18071/gentle-groove-cbd-gummies-sale/
https://www.facebook.com/SupermaxMaleEnhancement/
https://sites.google.com/view/supermax-male-review/home
https://supermax-male-enhancement-review.blogspot.com/2023/12/supermax-male-enhancement-review-boost.html
https://www.linkedin.com/events/supermaxmaleenhancement-improve7138809500244795392/
https://supermax-male-enhancement.hashnode.dev/supermax-male-enhancement-review-sexual-nutrients-to-boost-testosterone